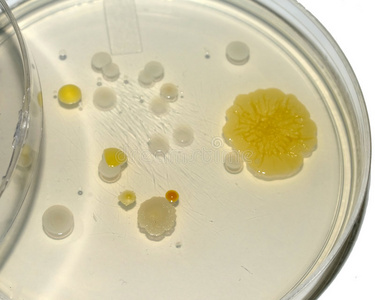
绿色菌落菌落沙门氏菌黑色细菌菌落在沙门氏菌志贺菌琼脂ss琼脂,选择

常见细菌菌落图片

如图 最近细菌总数测定发现菌落变了,这个是什么菌
图片尺寸700x934
细菌的菌落特征
图片尺寸875x802
帮忙签定细菌总数检测出来的菌落是什么菌?
图片尺寸1800x3200
【资源】发现一个细菌菌落精彩照片的新网站
图片尺寸640x512
四种颜色的细菌菌落在琼脂平板上,在黑色背景上分离
图片尺寸1106x1100
微生物菌落形态特征辨别
图片尺寸1840x3264
细菌菌落在琼脂平板上分离为黑色
图片尺寸1104x1100
此外,将菌落稀释然后使用细菌过滤器滤过后液体滴在正常的微球菌菌落
图片尺寸564x529
请问前辈们这是什么菌落呢?
图片尺寸2938x3917
霉菌分类之菌落观察——超清的菌落照片(答案在p7)
图片尺寸950x605
帮忙看一下这是什么菌落
图片尺寸1024x768
请教怎样根据菌落形态初区分细菌与放线菌
图片尺寸2336x4160
在黑色背景下分离的培养皿上的不同细菌菌落照片
图片尺寸317x300
图片中菌落主要是什么菌
图片尺寸1600x1200
【萌羽】-我们的手上沾满了别人的献血-杀手演绎
图片尺寸1631x1596
有图,帮助鉴定菌落
图片尺寸3456x2592
微生物菌落鉴别求助
图片尺寸1920x1920
观察下图中某种细菌在血平板上生长的菌落特点,描述最准确的是 - 上学
图片尺寸650x421
绿色菌落菌落沙门氏菌黑色细菌菌落在沙门氏菌志贺菌琼脂ss琼脂,选择
图片尺寸375x300
微生物馆_中国科普博览
图片尺寸355x450